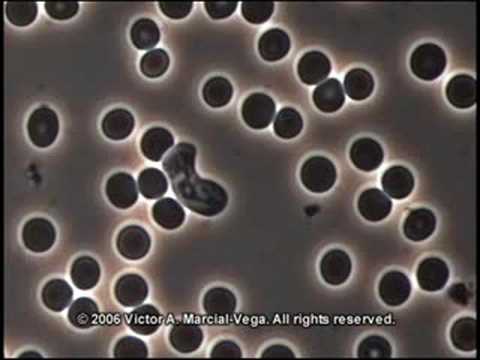
featured

JF Joy (48)
Hey it's JF Joy a nature lover. I like to talk about science and anything logical and try to watch nature as closely as possible.
4 followers6 posts1 following0 HP
Blacklisted UsersMuted UsersFollowed BlacklistsFollowed Muted Lists
Blacklisted UsersMuted UsersFollowed BlacklistsFollowed Muted Lists
Bangladesh utopiaeducators.com/author/md Joined July 2020 Active 5 years ago